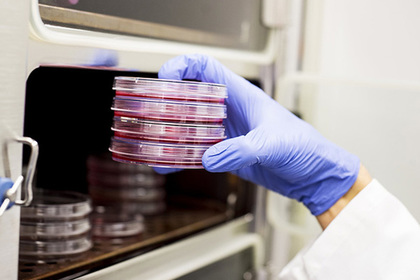

Новости: АмерикаБизнесБывший СССРИгрыИз жизниИнтернетКиноКиргизияКультураМасс-медиаМирМузыкаНаука и техникаО высокомОружиеПреступностьПрогрессРоссияСпортТехнологииУкраинаФинансыЭкономика
Все разделы
-
Наука и техника
-
Изобретена эффективная вакцина против агрессивного рака
|
| Рекламодателям | Добавить ресурс | Вход для владельцев ресурсов | На главную страницу портала faststart.ru |